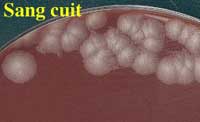

BACILLE DU CHARBON (Bacillus anthracis)
1/INTRODUCTION
La bactéridie de Davaine C. est bien connue des vétérinaires en France, car responsable d'une septicémie mortelle des herbivores, en particulier l'espèce bovine. Elle a été rapportée dans 23 départements au cours des 20 dernières années (Vaissaire J. Méd. Mal. Infect. 2001).

D'ailleurs la presse rapporte épisodiquement de petites épidémies animales.

La fièvre "médiatique" actuelle fait couler trop d'encre .......... et les biologistes médicaux broient du noir ......... devant l'afflux de demandes relatives à la mise en évidence de cette bactérie.

Le nombre de cas humains annuels est estimé par l'OMS entre 100 000 et 200 000. Le charbon bactéridien se présente sous, au moins trois formes, reflétant la voie de contamination, chacune susceptible de se compliquer de méningite ou de septicémie très grâves. Il s'agit le plus souvent d'une maladie professionnelle.
. La forme cutanée est la plus fréquente (90-95 %). Elle se traduit après 3 - 5 jours d'incubation par l'apparition d'une papule rouge, puis d'une vésicule prurigineuse avec un œdème envahissant les tissus voisins laissant une escarre noirâtre progressant de façon centrifuge. Dans 90 p. cent des cas, la guérison est spontanée. Lors d'une forme sévère, il y aura une adénite régionale et parfois une septicémie mortelle en l'absence de traitement.

 |
 |
Pour en savoir plus : http://www.atlas-dermato.org
. Le charbon d'ingestion, rare chez nous, se traduit par des troubles généraux (fièvre, état de choc) et digestifs (douleurs abdominales, vomissements, diarrhée sanglante) après une incubation de 2 - 7 jours. Le taux de mortalité est élevé.
. Le charbon d'inhalation ou pulmonaire, habituellement lié à certaines professions (lainiers) est évoqué lors de bioterrorisme avec un temps moyen d'incubation de 10 jours, mais les premiers cas apparaissant après 48 heures. Les symptômes initiaux les plus souvent rapportés sont de la fièvre, une petite toux non productive, des myalgies, malaises ; somme toute, ces symptômes ressemblent à une infection respiratoire supérieure telle la grippe (Phase 1)
Phase 2 : Puis les radiographies vont montrer un élargissement du médiastin, lié à une médiastinite hémorragique pouvant être accompagnée d'une effusion pleurale.
Phase 3 : Après 1 à 2 jours, la maladie évolue très rapidement avec dyspnée, toux stridente, frissons et mort. Le temps moyen entre ces symptômes respiratoires et la mort est de 3 jours. En l'absence de traitement, son évolution est mortelle dans plus de 95 % des cas.
2/DIAGNOSTIC BACTERIOLOGIQUE
Cette bactérie appartient à la classe biologique 3

- Prélèvements
1- Cas de patients "suspectés" cliniquement (symptomatologie +++)
Il apparaît que le diagnostic bactériologique est le plus souvent positif à partir de : sang, LCR, sérosité (papule)....
2- Cas particuliers du patient arrivant aux Urgences dans un contexte d'éventuelle contamination
- Poudre suspecte : à adresser à la police ou gendarmerie qui s'assure de celle-ci pour examen dans un laboratoire spécialisé.
- Narine : conformément aux instructions des autorités de tutelles, effectuer un prélèvement dès son arrivée (avant la douche) à l'aide d'un écouvillon plongé stérilement dans du sérum physiologique. Celui-ci sera introduit dans un emballage plastique et adressé au laboratoire. Préciser la demande sur la feuille d'examen qui sera adressée séparément dans un emballage isolant. Leur analyse pourra être différée jusqu'à la réception des résultats de l'analyse de la source dans un laboratoire spécialisé.
3- Cas particuliers du patient arrivant aux Urgences dans un contexte d'attaque réelle par inhalation (USA actuellement)
il est possible de rechercher la présence de spores
- Narine +++ (cf. ci-dessus)
- Front : par ensemencement par simple contact de géloses "Count-Tact".
- Mains: apposer la pulpe des doigts à la surface d'une gélose au sang frais
| - Examen microscopique . A l'état frais, il s'agit d'une bactérie immobile mais sous la forme souvent de grands bacilles à bouts carrés. On recherchera la présence de spores non déformantes en position sub-terminale ou centrale (réfringence ++) après 48 à 72 h d'incubation. Pour en savoir plus : http://www.ens-lyon.fr (spore) |
 |
Quelquefois, ce bacille est capsulé dans les produits pathologiques. La capsule peut-être visualisée par la technique à l'encre de chine.
. Coloration de Gram : Bacilles à Gram-positif à bouts carrés de 2 à 5 µm, souvent en filaments. Lorsque l'examen des colonies est effectué après 48-72 h en aérobiose, il est possible de mettre en évidence, la présence de spores (non déformantes en position sub-terminale ou centrale).
 |
 |
 |
|
- Culture
. La détection en automate d'hémoculture est rapide (dès la 5 ème heure d'incubation)(Bact'Alert®). La température optimale de croissance est comprise entre 30 - 35°C.
. Les prélèvements tels écouvillons humidifiés (bouillon, sérum physiologique) seront ensemencés sur une gélose au sang frais (1) et une gélose chocolat enrichie de type Polyvitex® (2) puis incubés dans un container isolant à 37°C en aérobiose. Les cultures seront examinées après 24, 48 et 72 h d'incubation. La culture de cette bactérie est rapide.
Pour des raisons d'urgence et de risque hautement probable, il est possible d'examiner les géloses au sang frais et chocolat après 6-8 heures d'incubation en aérobiose: les colonies présentent un aspect de type "givrage" ou "mica" comme ci-dessous
 |
 |
L'aspect caractéristique des colonies en aérobiose est identique à celui de la culture de B. cereus. Il s'agit en 18 h, de colonies de 2 à 4 mm d'épaisseur à bord découpés, sèches, donc rugueuses. On notera l'absence d'hémolyse ou très faible (après 48 h).
Aspect des colonies après 18 h à 37°C

|
Aspect des colonies après 48 h à 37°C
|
||
 |
|
 |
Milieux inappropriés: Bien que bacille à Gram-positif, l'isolement sur la gélose au sang frais de type ANC (acide nalidixique, colimycine) est déconseillé en raison de l'inhibition possible. Enfin, la culture sur le milieu de Drigalski est toujours négative.
. La culture en milieu liquide montre, après quelques heures d'incubation, des flocons puis un sédiment blanc. Ce bacille aéro-anaérobie préfère, cependant, les conditions d'aérobiose

- Identification
Catalase + , Nitrates +, Pouvoir protéolytique faible : en gélatine nutritive, la liquéfaction est très lente la bactérie pousse tout le long puis en une huitaine de jours montre dans la partie supérieure, un aspect en sapin renversé. Le sérum coagulé est digéré lentement.
Quelques sucres sont fermentés : glucose, maltose, saccharose et le VP est positif. Quelques autres caractères peuvent être recherchés: amylase, lécithinase.
EN PRATIQUE:
. Ensemencer une galerie API20E avec un inoculum plus dense que pour une entérobactérie. Les caractères sont faiblement positifs en 24 heures : VP, gélatinase, glucose (en particulier jaunissement de la zone en aérobiose) et nitrates.


A partir de ces éléments, la confirmation sera recherchée en ensemencent une galerie API 50CH (cf modèle ci-dessous):
Les caractères positifs en 24 heures sont les suivants : saccharose, ribose, glucose, fructose, esculine, maltose, saccharose, tréhalose et NAG. Pour d'autres substrats 36, 37, 47, ils sont positifs en 2 à 3 jours d'incubation.

- Autres examens
. La PCR permet la caractérisation finale d'autant que plusieurs jeux d'amorces peuvent être utilisées, compte tenu de travaux récents sur l'individualisation des facteurs de virulence et d'une séquence spécifique chromosomique (Ba823). B.anthracis est très proche de B. cereus mais la séquence Ba823 est spécifique.
La souche est à adresser à l'Institut Pasteur, unité des Toxines et Pathogénie Bactériennes de M. Mock

. L'inoculation expérimentale au cobaye est peu utilisée maintenant. L'animal meurt rapidement (24-48 h) de septicémie.
3/DIAGNOSTIC INDIRECT sérologique et allergique de moindre d'intérêt.
. Le diagnostic sérologique (ELISA. ou Western blot) semble d'un usage courant dans certains pays, notamment pour des études épidémiologiques et rétrospectives.
. Le diagnostic allergique (Anthrax Skin test) mettant en évidence une réaction locale d'hypersensibilité, est peu onéreux et permet un diagnostic précoce. Ce test, utilisé dans les pays de l'Est depuis 1957, permet d'évaluer la protection conférée chez l'homme par un vaccin vivant atténué.
4/SENSIBILITE AUX ANTIBIOTIQUES
La méthode en milieu gélosé par diffusion ou avec des bandelettes E-test sera privilégiée avec les précautions d'usage. Cette espèce est sensible à de nombreux antibiotiques in vitro dont la pénicilline G (0,06 - 0,12 ug/ml)(P)

Le phénotype de résistance aux autres ß-lactamines est caractéristique, très différent de celui de B. cereus : sensible à l'amoxicilline (0,03-0,06 µg/ml)(AMX) ainsi qu'à son association avec l'acide clavulanique (AMC), ticarcilline (TIC), céfalotine (CF). On notera la résistance aux C3G dont la ceftazidime (CAZ).

La résistance acquise aux pénicillines est maintenant rapportée en France et liée à la présence de ß-lactamase. Le choix de cette famille d'antibiotiques en première intention est actuellement exclue (cf. physio-pathogénie).
La sensibilité in vitro aux autres antibiotiques (aminoglycosides telle gentamicine (G), fluoroquinolones telle ciprofloxacine (CIP), macrolides (E), tétracyclines (TET) , glycopeptides) est montrée ci-dessous:



Le choix au plan clinique se portera, pour la forme pulmonaire, sur la ciprofloxacine (CIP)(0,06 µg/ml), tétracycline (TET)(0,06 µg/ml), doxycycline (0, 03 µg/ml), érythromycine (E)(1 µg/ml), clarithromycine (0,25 µg/ml), rifampicine (0.5 µg/ml), vancomycine (VAN), chloramphénicol (4 µg/ml)
Dans la cadre actuel d'une éventuelle inhalation de spores, l'antibiotique de choix en antibioprophylaxie est la ciprofloxacine (Ciflox®), à raison de 500 mg per os deux fois par jour (ou une autre fluoroquinolone systémique) pendant 3 jours, y compris pour les enfants (20 à 30 mg/kg).
Si la source n'est pas disponible pour être analysée, les sujets contacts devront recevoir une prophylaxie de 60 jours.
Compte tenu des circonstances présentes, nos connaissances sur cette bactérie prennent une acuité particulière et peuvent être enrichies sur les sites suivants :
| http://www.afssaps.sante.fr/ http://www.cdc.gov http://www.bact.wisc.edu/bact330/lectureanthrax http://www.vetmed.lsu.edu/whocc/mp_world.htm http://www.microvet.arizona.edu/ |
Références bibliographiques
- Drobniewski FA . Bacillus cereus and related species. Clin Microbiol Rev 1993; 6: 324-338.
- Keim P, Price LB, Klevytska AM, Smith KL, Schupp JM, Okinka R, et al. Multiple-Locus Variable-Number tandem repeat analysis reveals genetic relationships within Bacillus anthracis. J Bacteriol 2000 ; 182 : 2928-36.
- La Force FM. Anthrax. Clin Infect Dis 1994 ; 19 :1009-1013.
- Makino S, Cheun H, Watari M, Ucheda I, Takeshi K: Detection of anthrax spores from the air by real-time PCR. Lett Appl Microbiol 2001, 33, 237 - 240
- Mock M., Gouet A. Anthrax. Annu. Rev. Microbiol., 2001, 55: 647-671.
- Ramisse F, Hernandez E, Goasdoue JL.Bacillus anthracis et guerre biologique. Bull Soc Fr Microbiol 1998, 13, 145-151.
- Sirad JC, Malville M, Fouet A, Mock M. Physiopathologie moléculaire de la maladie du charbon. Rev Méd Vét 1996, 147, 653-670.
- Smith KL, De Vos V, Bryden HH, Price LB, Hugh-Jones ME, Keim P. J Clin Microbiol. 2000, 38: 3780-3784.
- Vaissaire J. Le charbon bactéridien: accident professionnel d'hier, et toujours présent. Bull Acad Vét Fr 1997 ; 70 : 93-100.
- Vaissaire J, Mock M, Le Doujet C, Lévy M. Le charbon bactéridien. Epidémiologie de la maladie en France. Méd Mal Infect 2001 ; 31 Suppl 2 : 257-271.
Cette fiche a été préparée par le Pr. Philippon A. et le Dr. Bernier M. (CHU Cochin-Port-Royal) avec la collaboration du Pr. Cavallo JD (Hôpital d'Instruction des Armées Bégin) et le Dr. Vaissaire J (AFSSA)
|
|
|
|
|